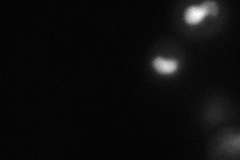
YLR032W
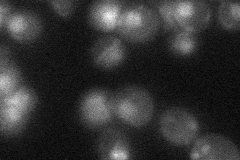
YLR032W

View description
DNA helicase proposed to promote replication fork regression during postreplication repair by template switching; RING finger containing ubiquitin ligase; stimulates the synthesis of free and PCNA-bound polyubiquitin chains by Ubc13p-Mms2p
Localization:
Intensity:
Fold change:
Significance:
-
C’ GFP library in SD

nucleus22.05 -
N' NOP1pr-GFP in SD
nucleus51.9767 -
N' TEF2pr-mCherry in SD

nucleus53.3375 -
N' NATIVEpr-GFP in SD
nucleus24.7951 -
N' TEF2pr-VC and Cyto-VN in SD

#N/A0 -
C’ GFP library in SD+DTT

nucleus16.140.73Yes -
C’ GFP library in SD+H2O2

nucleus22.531.02No -
C’ GFP library in Starvation Media

nucleus17.90.81Yes -
C’ GFP library on the background of Pup2-DaMP

nucleus -
C’ GFP library on the background of CCT mutant

nucleus19.9320.903679No
